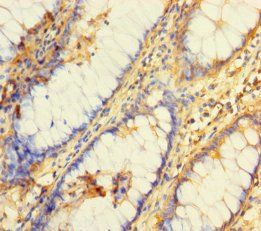
BRCC3 Antibody

You have no items in your shopping cart.
Description
Images & Validation
−| Tested Applications | ELISA, IHC, WB |
|---|---|
| Reactivity | Bovine, Human |
Key Properties
−| Antibody Type | Primary Antibody |
|---|---|
| Host | Rabbit |
| Clonality | Polyclonal |
| Conjugation | Unconjugated |
Storage & Handling
−| Storage | Maintain refrigerated at 2-8°C for up to 2 weeks. For long term storage store at -20°C in small aliquots to prevent freeze-thaw cycles. |
|---|---|
| Form/Appearance | Liquid |
| Concentration | Lot dependent |
| Expiration Date | 12 months from date of receipt. |
| Disclaimer | For research use only |
Alternative Names
−Similar Products
−DEPDC1B/BRCC3 Rabbit Polyclonal Antibody [orb183064]
IF, IHC-Fr, IHC-P, WB
Bovine, Mouse, Rabbit, Rat
Human
Rabbit
Polyclonal
Unconjugated
50 μl, 100 μl, 200 μlBRCC36/BRCC3 Rabbit Polyclonal Antibody [orb865364]
ELISA, FC, ICC, IF, WB
Human, Mouse, Rat
Rabbit
Polyclonal
Unconjugated
100 μgBRCC3 Rabbit Polyclonal Antibody [orb585188]
IF, WB
Bovine, Equine, Guinea pig, Mouse, Porcine, Rabbit, Rat
Human
Rabbit
Polyclonal
Unconjugated
100 μl

Quality Guarantee
Explore bioreagents carefree to elevate your research. All our products are rigorously tested for performance. If a product does not perform as described on its datasheet, our scientific support team will provide expert troubleshooting, a prompt replacement, or a refund. For full details, please see our Terms & Conditions and Buying Guide. Contact us at [email protected].

Western blot analysis was performed using anti-BRCC3 polyclonal antibody at 1 µg/mL on recombinant BRCC3 (Catalog No. orb3149652).
Documents Download
Request a Document
Protocol Information
BRCC3 Polyclonal Antibody (orb3149653)
Participating in our Biorbyt product reviews program enables you to support fellow scientists by sharing your firsthand experience with our products.
Login to Submit a Review